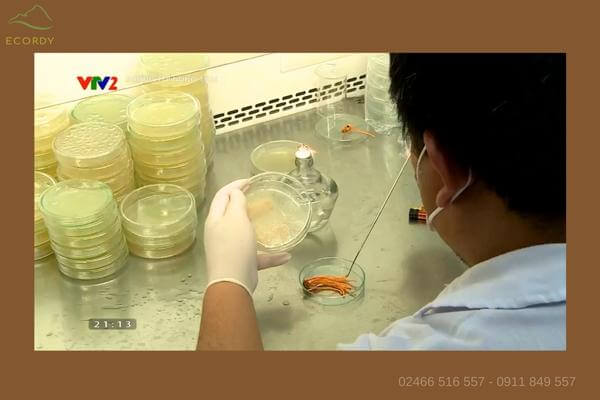
Quá trình nhân giống đông trùng hạ thảo tại Viện Bảo vệ Thực vật

Cs2: 211A Thụy Khuê, Thụy Khuê, Tây Hồ, HN.
Bộ môn Côn trùng và Tuyến trùng – Viện Bảo vệ thực vật là đơn vị sự nghiệp khoa học, trực thuộc Viện Khoa học Nông nghiệp Việt Nam.
Với chuyên môn nghiên cứu về các loại côn trùng, chúng tôi đã nghiên cứu và nuôi cấy thành công sản phẩm Đông trùng hạ thảo Cordyceps Militaris - bản chất là một loại nấm ký sinh trên côn trùng.
Hơn 10 năm đưa sản phẩm ra thị trường thông qua các đơn vị đối tác thương mại, sản phẩm do chúng tôi nuôi cấy nhận được nhiều phản hồi tích cực và được đón nhận rộng rãi.
Sản phẩm rất phù hợp để các bạn bồi bổ sức khỏe, tăng cường dưỡng chất và là một món quà ý nghĩa, độc đáo các bạn có thể lựa chọn dành cho người thân, gia đình, bạn bè, đối tác.
Chúng tôi luôn sẵn sàng hợp tác chuyển giao công nghệ, cung cấp giống Đông trùng hạ thảo cho các tổ chức, cá nhân có nhu cầu.
Xem các video về Đông trùng hạ thảo Bộ môn Côn trùng và Tuyến Trùng - Viện Bảo vệ thực vật TẠI ĐÂY
xem thêm...
-
Mua ngay
xem chi tiết
ECORDY NGUYÊN CON TƯƠI hộp lớn
-
Mua ngay
xem chi tiết
ECORDY NGUYÊN CON TƯƠI hộp vừa
-
Mua ngay
xem chi tiết
ECORDY NGUYÊN CON TƯƠI hộp nhỏ
-
Mua ngay
xem chi tiết
ECORDY NGUYÊN CON KHÔ hộp lớn
-
Mua ngay
xem chi tiết
ECORDY NGUYÊN CON KHÔ hộp vừa
-
Mua ngay
xem chi tiết
ECORDY NGUYÊN CON KHÔ hộp nhỏ
-
Mua ngay
xem chi tiết
ECORDY SỢI KHÔ hộp lớn
-
Mua ngay
xem chi tiết
ECORDY SỢI KHÔ hộp vừa
-
Mua ngay
xem chi tiết
ECORDY SỢI KHÔ hộp nhỏ
-
Mua ngay
xem chi tiết
BỘT ECORDY
-
Mua ngay
xem chi tiết
ECORDY SINH KHỐI TƯƠI loại đẹp
-
Mua ngay
xem chi tiết
Giống Đông trùng Hạ thảo
Đông trùng hạ thảo Ecordy - Viện Bảo vệ Thực vật: Chất lượng và Uy tín Từ Năm 2014
Đông trùng hạ thảo là một loại nấm dược liệu quý hiếm, được biết đến với khả năng hỗ trợ tăng cường sức khỏe và cải thiện đề kháng tự nhiên. Trong số các chủng Đông trùng hạ thảo, Cordyceps militaris là một trong những chủng phổ biến và có giá trị cao.
Tại Viện Bảo vệ Thực vật, chúng tôi tự hào mang đến sản phẩm Đông trùng hạ thảo Ecordy, được sản xuất với công nghệ tiên tiến và quy trình nghiêm ngặt từ năm 2014, đảm bảo chất lượng dược liệu đạt chuẩn.
Video giới thiệu Đông trùng hạ thảo Bộ môn Côn trùng và Tuyến trùng - Viện Bảo vệ Thực vật
Quy trình sản xuất đạt chuẩn ISO 22000-2018
Sản phẩm Đông trùng hạ thảo Ecordy của Viện Bảo vệ Thực vật được nuôi cấy và kiểm soát trong môi trường đạt tiêu chuẩn quốc tế, với sự tham gia của đội ngũ chuyên gia giàu kinh nghiệm:
- Tiến sĩ Nguyễn Thị Thủy – Chủ nhiệm bộ môn, chủ nhiệm nhóm nghiên cứu.
- Thạc sĩ Đỗ Duy Trọng – Phó chủ nhiệm nhóm.
- Thạc sĩ Trần Thị Thúy Hằng, thành viên nhóm.
- Thạc sĩ Nguyễn Thị Mai Lương, thành viên nhóm.
- Thạc sĩ Nguyễn Thị Hoa, thành viên nhóm.
Chúng tôi kiểm soát chặt chẽ từng bước trong quá trình sản xuất, từ chọn giống, bảo tồn giống, đến kiểm soát nhiệt độ, ánh sáng, và đảm bảo vệ sinh môi trường nuôi cấy. Điều này giúp sản phẩm Đông trùng hạ thảo Ecordy có hàm lượng dược tính cao và an toàn cho người sử dụng.

Nhóm nghiên cứu Đông trùng Hạ Thảo Viện Bảo vệ Thực vật
Chất lượng được đảm bảo qua từng chi tiết sản phẩm
Sản phẩm tươi:
- Có màu sắc tự nhiên, sáng tươi, sợi nấm chắc khỏe, dược tính cao.
- Mùi ngái đặc trưng, nếm có vị ngọt nhẹ - dấu hiệu của một sản phẩm chất lượng.
Sản phẩm khô:
- Sợi nấm vẫn giữ được độ tươi và mùi thơm đặc trưng.
- Nấm có màu sắc tươi tắn, sợi căng không bị xoắn, đảm bảo vẫn giữ nguyên dược tính sau quá trình sấy đông khô.
| Chi tiết: Thạc sĩ Trần Thị Thuý Hằng hướng dẫn cách chọn sản phẩm Đông trùng hạ thảo tốt.
Quá trình nhân giống đông trùng hạ thảo tại Viện Bảo vệ Thực vật
Đông trùng hạ thảo Ecordy có gì đặc biệt?
Được sản xuất bởi Bộ môn Côn trùng và Tuyến trùng - Viện Bảo vệ Thực vật, sản phẩm Đông trùng hạ thảo Ecordy nổi bật với quy trình kiểm soát chất lượng nghiêm ngặt, từ khâu nuôi cấy đến khi đóng gói.
Không chỉ vậy, sản phẩm còn được kiểm định theo tiêu chuẩn ISO 22000-2018, đảm bảo không có sự phát triển của nấm lạ, gây ảnh hưởng đến sức khỏe người tiêu dùng.
Đông trùng hạ thảo Ecordy viện Bảo vệ Thực vật có những loại nào, giá bao nhiêu?
Chúng tôi cung cấp đa dạng các loại sản phẩm để phù hợp với nhu cầu của khách hàng:
1. Loại Nguyên con tươi (xem chi tiết TẠI ĐÂY): Có dạng các sợi quả thể nấm mọc từ ký chủ nhộng tằm. Có giá từ 860 ngàn/1 hộp.
2. Loại Nguyên con khô (xem chi tiết TẠI ĐÂY): Có dạng các sợi quả thể nấm mọc từ ký chủ nhộng tằm, được sấy đông khô ở âm 50 độ C. Có giá từ 1tr350 ngàn/1 hộp.
3. Loại Sinh khối tươi nguyên đế (xem chi tiết TẠI ĐÂY): Có dạng các sợi quả thể nấm mọc từ đế sinh khối gạo lức và nhộng tằm xay. Có giá từ 390 ngàn/hộp.
4. Loại Sợi quả thể khô (xem chi tiết TẠI ĐÂY): Có dạng các sợi quả thể nấm mọc từ đế sinh khối gạo lức và nhộng tằm xay. Sợi nấm ngắt ra sấy đông khô ở âm 50 độ C. Có giá từ 450 ngàn/hộp
5. Loại Bột (xem chi tiết TẠI ĐÂY): Đế sinh khối tươi sấy khô cùng sợi quả thể khô nghiền bột. Có giá từ 450 ngàn/hộp.
Mua Đông trùng hạ thảo Ecordy viện Bảo vệ Thực vật chính hãng ở đâu?
Để đảm bảo chất lượng và hiệu quả của sản phẩm, bạn nên lựa chọn mua Đông trùng hạ thảo Ecordy viện Bảo vệ Thực vật chính hãng tại các cửa hàng uy tín được uỷ quyền phân phối.
Khách hàng có thể đặt mua Online hoặc đến mua trực tiếp theo địa chỉ:
Cơ sở 1: Số 7 Thái Thịnh, Ngã Tư Sở, Đống Đa, Hà Nội (cạnh đèn đỏ Thái Thịnh giao Tây Sơn, ô tô đỗ cửa)
Cơ sở 2: Số 211A Thụy Khuê, Thụy Khuê, Tây Hồ, Hà Nội (đối điện UBND Phường Thụy Khuê, ô tô đỗ cửa)
Hotline: 02466.516.557 - 0911.849.557
XEM THÊM:
Xem thêm...Từ khi tôi dùng ĐTHT Ecordy, sản phẩm chất lượng đâm ra người tôi khoẻ như thanh niên, làm cả ngày không thấy mệt mỏi gì cả.
.
Kiêu Kị, Gia Lâm, Hà Nội
Xin gửi lời chúc chân thành nhất của bác đến cơ quan nuôi cấy đông trùng hạ thảo Ecordy luôn mạnh khoẻ, phát triển sản phẩm của mình đến mọi người, mọi nhà đều được sử dụng.
Tiền Phong, Mê Linh, Hà Nội
Tìm ra phương pháp làm đẹp da, chống lão hóa luôn là mối quan tâm của chị em phụ nữ. Đông trùng hạ thảo-một thảo dược quý đã được sử dụng làm phương thuốc dưỡng nhan cho các quý phi hoàng hậu vô cùng hiệu quả. xem chi tiết
Đông trùng hạ thảo là loại thảo dược quý được biết với hàng ngàn công dụng bổ dưỡng sức khỏe. Tham khảo vài biết sau để tìm hiểu cách dùng Đông trùng hạ thảo đúng cách nhé. xem chi tiết
Ngoài cách ngâm với rượu, ngâm mật ong... Bài viết này sẽ chia sẻ với mọi người những cách chế biến đông trùng hạ thảo thành những món ăn ngon và bổ dưỡng nhất xem chi tiết
Đông trùng hạ thảo (ĐTHT) có thực sự giúp ích nhiều cho đời sống tình dục hay không? ngoài ra nó còn có công dụng gì khác? Hãy cùng tìm hiểu bài viết sau xem chi tiết
5 out of 5 with 20 ratings
ĐỊA CHỈ MUA HÀNG:
Cửa hàng Tây Hồ: Số 211A Thụy Khuê, Thụy Khuê, Tây Hồ, Hà Nội (đối điện UBND Phường Thụy Khuê, ô tô đỗ cửa).
Giờ mở cửa: T2-T7: 8h00-21h00. Chủ nhật: 8h30-17h00.
Cửa hàng Ngã Tư Sở: Số 7 Thái Thịnh, Ngã Tư Sở, Đống Đa, Hà Nội (gần đèn đỏ giao Tây Sơn)
Giờ mở cửa: T2-T7: 8h00-21h00. Chủ nhật: 8h30-17h00.
Phòng nuôi: Viện Bảo vệ Thực Vật, Phố Viên, Đức Thắng, Bắc Từ Liêm, Hà Nội.
Thông báo: Cơ sở cũ tại số 8 Nguyễn Viết Xuân chuyển địa điểm sang cơ sở mới tại số 7 Thái Thịnh từ ngày 10/01/2024.
Hotline: 0911 849 557
GIAO HÀNG MIỄN PHÍ ĐƠN HÀNG TỪ 1 TRIỆU, NỘI THÀNH HÀ NỘI GIAO TRONG 2H.


Đăng Nhập
Giỏ hàng

